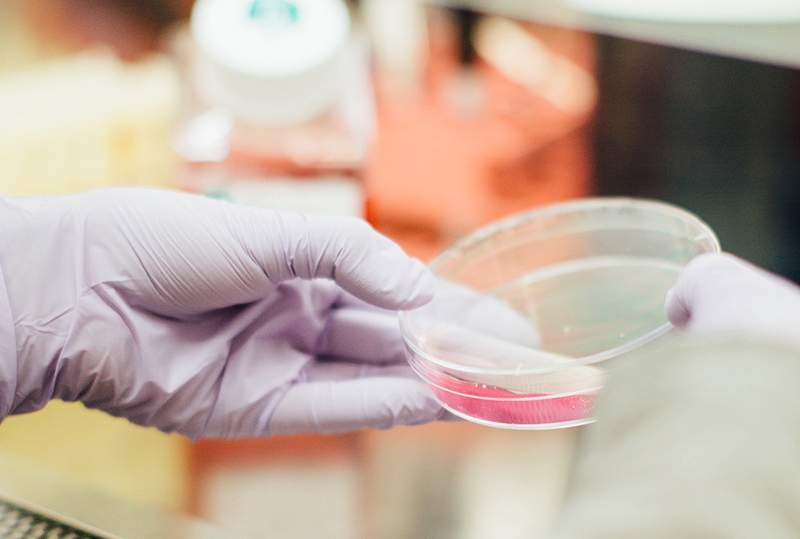

Distribuidor Clínico de Reactivos
para Laboratorio
NUESTRA EMPRESA TIENE PRESENCIA EN LOS ESTADOS DE DURANGO, COAHUILA Y CHIHUAHUA
- Abastecemos insumos y reactivos para laboratorio
- Brindamos el servicio de mantenimiento preventivo y correctivo a equipos de laboratorio

Venta de Analizadores de Inmunoensayo por Quimioluminiscencia Flash SNIBE MAGLUMI 800, X3, X6 ,X8, REACTIVOS y consumibles SNIBE MAGLUMI.
Productos destacados de DCRLAB

Química clínica

Hematología

Inmunología

Microbiología

Coagulación

Diabetes

Pruebas rápidas

Antidoping

Toma de muestra
